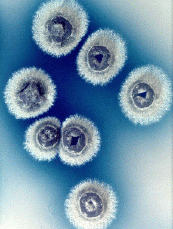

Tour of Microbes Tour Home | Disease Home | Microbes A to Z | Bio 203 Home |

Streptomyces colonies on
agar
Streptomyces mycelium
Streptomyces forms one of the most important antibiotic-producing bacterial groups. It is a filamentous actinomycete with hyphae and (external) spores. The colonies seen in this photo show the presence of the mycelium and the colorful spores.
Domain Bacteria
Phylum Actinobacteria
Class Actinobacteria
Bergey's Manual Volume 5: The Actinobacteria